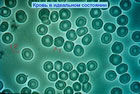

90971 (679601), страница 3
Текст из файла (страница 3)
Комментарий специалиста: темнопольное гемосканирование не может отобразить кислотно-основное состояние крови. Любопытно, что никаких сравнений информативности этого метода с другими лабораторными методами диагностики не проводится(1,2,3,5,16).
Микроскопические исследования крови, которые я сейчас покажу, скорее всего, вы уже видели в процессе своих наблюдений. Мне бы хотелось, чтобы мы все сегодня работали как бы на одном уровне. Иногда бывает такое, что мы боимся признаться, в том, что мы чего-то не знаем. Много лет назад я понял, что я многое в жизни не знаю. Мне сообщила об этом моя жена, сразу же после свадьбы. Мне приходилось много раз говорить: «Я многое не знаю в жизни». Но когда я что-то не знаю, я пытаюсь найти ответ на интересующий меня вопрос.
У нас есть очень интересные документы, которые мы можем использовать – это мое издание, как я в шутку называю - библия темнопольного микроскопа. Это достаточно старая книга, но, к сожалению, когда издаются новые, они не всегда лучше. Из книги понятно, что самая главная задача при использовании темнопольного микроскопа это решить, каким образом вернуть организм назад к нормальному кислотно-щелочному балансу.
Комментарий специалиста: у кого сколько фантазии для описания увиденной картинки…
У нас есть десять мест в организме, где можно измерить pH. В практической деятельности мы чаще концентрируемся на крови, потому что у неё очень маленький диапазон изменений в различные стороны изменения pH и поэтому более объективные результаты. Во всех остальных местах этот диапазон изменений значительно шире, что может дать нам неправильную информацию.
Слюна, например, может быть использована, для того чтобы измерять pН. Но только, если это делается правильно - только когда мы просыпаемся утром. Именно утренний замер рН слюны является самым максимально объективным. Вам нужно сделать два глотательных движения, чтобы слюна выделялась и до замера проглотить её дважды. Затем использовать индикаторную бумагу под языком, для того чтобы подчелюстные железы, выделяющие слюну, могли бы дать правильную информацию. Такое исследование нужно делать три дня подряд, а затем взять средний показатель. И только это значение может быть максимально приближенным к вашему кислотно-щелочному балансу.
Почему утром получается самый точный замер? Поясняю: во время сна происходит использование щелочных элементов, которые находятся в нашем организме, нашими органами и железами. Самое легкое место, где можно украсть микроэлементы - это именно слюнные железы. Поэтому к утру мы становимся более истощенными в отношении - К, Na, Мg, Са. Другими словами, утро – это время, когда мы должны быть максимально щелочными. Если делать этот тест слюны позже, в течение дня, то вся поглощаемая нами еда, безусловно, повлияет на правильность замера рН. Например, соль - щелочная. Если вы съедаете соленую пищу и после этого быстро замеряете рН слюны, то получите великолепное значение рН слюны, но на самом деле организм человека может быть весьма и весьма закислен.
Во время моей презентации я буду вам говорить о двух серьезных вещах, которые касаются pН. Это pН крови - значение которого меняется в очень узком диапазоне. И общий pН человеческого организма, который, как мы обнаружили, в разных точках может быть разным, но в среднем должен быть – 7,4. Именно при этом значении pН, наши обменные процессы находятся на максимально высоком уровне, а уровень энергии максимален. Мы как здоровый чистый двигатель, в котором все сгорает и не остается никаких шлаков. И самое главное это то, что именно в этом состоянии иммунная система находится на пике своего подъёма. Мы знаем, что как только человеческий организм двигается в направлении закисления – наступает время, когда начинаются болезни. Это не новая информация. Она известна людям на протяжении 2000 лет. Это базовые понятия инь и янь. К сожалению, в нашем западном мире, мы узнали об этом только в 30-х годах прошлого века. Вотун Арбург, сделал открытие, за которое получил Нобелевскую премию. Он доказал, что раковые клетки не могут воспроизводиться и множиться в щелочной среде, насыщенной кислородом. С того времени мы узнали и поняли, что это касается абсолютно всех болезней, а не только рака. Вообще причиной болезней является закисление организма, происходящее с помощью: бактерий, вирусов, грибков, дрожжевых инфекции и так далее. В настоящее время мы уже знаем, что процессы закисления связаны с процессом старения и со старческими заболеваниями, такими как, остеопороз, болезнь Альцгеймера. Все они являются болезнями, которые абсолютно четко связаны с закислением человеческого организма и с ухудшением его состояния. Мы знаем, что если сможем возвратить человеческий организм к нормальному уровню рН и не просто поднять, а удержать кислотно-щелочной баланс на этом уровне, то наступит исцеление. Самая большая проблема, которую мы сейчас видим – это именно удержать этот уровень. Очень большое количество заболеваний, о которых я сказал, приостанавливают свое развитие, состояние человека улучшается, т.е. болезнь уходит. Как я уже сказал удержать кислотно-щелочное равновесие тканей на уровне нормального состояния рН – это проблема, потому что все наши действия приводят к выработке кислоты. Мы созданы щелочными, но являемся кислото-вырабатывающим организмом.
Комментарий специалиста: названная теория ничем не подтверждена(1,2,3,5,11,16,24).
Если бы вы были моими пациентами, я бы вас попросил сделать 5 вещей, для того, чтобы уменьшить нагрузку на организм и снизить закисление тканей:
-
Не курить или бросить курить (но я боюсь, что для некоторых европейцев это невозможно).
-
Мы должны следить за уровнем сахара и постараться избежать в нашей еде белого рафинированного сахара. В нём нет ни одного полезного элемента. Все рафинированные и переработанные продукты – это те продукты, которые нам дадут те или иные проблемы в отношении здоровья.
-
Также очень вредоносна белая мука, из которой при обработке удаляют необходимые питательные вещества. В белой муке, нет ни одного полезного вещества, ни одного полезного элемента. Плохой холестерин (низкой плотности) приносит нам много проблем. В то же время хороший холестерин (высокой плотности) создается в организме, после того как мы едим цельные зерна, т.е. все цельное.
Комментарий специалиста: продукты растительного происхождения не содержат холестерин, его содержат жиры животного происхождения.
-
Вы должны перестать пить абсолютно любые газированные напитки – это то, что сейчас медленно убивает нашу молодежь. Могу сказать, что все, что я сказал по поводу муки и сахара, верно и для этих напитков, где нет ни одного полезного элемента. Все красители, и то, что там находится - на 100% очень вредно для человека. Все эти цветные напитки в тысячи раз более кислые, чем просто чистая вода. Некоторые люди говорят: «Все в порядке, я же пью «диетическую колу»», скажу вам: диетические - ещё хуже.
-
Это аспартам – или все, что касается искусственных подсластителей. Аспартам еще более кислый, чем Coca-cola. Но и это не является в принципе самой главной проблемой. При температуре выше 30 с небольшим градусов по Цельсию (т.е. чуть ниже температуры человеческого тела), аспартам превращается в формальдегид. Известно, что формальдегид – это серьезный яд, который требует от нашей поджелудочной железы колоссальной работы, для того чтобы его переработать и разрушить. Поэтому мы имеем от одного продукта две проблемы: закисление и токсическое действие подсластителей на наши органы.
Если мы будем придерживаться этих правил, то повернём нашу жизнь в лучшую сторону на 180 градусов. И для многих из наших пациентов – это единственное, что им необходимо. Но конечно, есть и такие, которым требуется и дополнительная помощь. И это именно тот момент, когда нам надо сконцентрироваться на их правильном питании и на биологически активных добавках.
Наша задача, как квалифицированных специалистов в восстановлении здоровья, с помощью различных средств и методов привести человеческий организм к нормальному кислотно-щелочному балансу. В этом нам и нашим пациентам поможет темнопольный микроскоп, как очень хороший инструмент.
В основном все проблемы, происходящие в нашем организме, связаны с двумя видами патогенной флоры, которые очень хорошо взаимодействуют друг с другом. Это Mucor и aspehgillius- самая примитивная и начальная форма, которая живет в содружестве с нашим телом. Когда в нашем теле рН меняется в более кислую сторону, эти микроорганизмы переходят в следующие формы: primativ, intermediate, term (lavanced) - они становятся более агрессивными. С помощью микроскопа мы редко видим форму primativ , чаще всего - intermediate и очень часто последнюю форму term. Как доктора натуропатии мы не лечим болезни, мы воздействуем на причины этих болезней, возвращая наш организм к нормальному кислотно-щелочному балансу. Более того, очень часто нам нужна именно primativ – это состояние баланса. Когда наш организм уходит от нормального кислотно-щелочного баланса в дисбалансированное состояние, форма intermediate включает патологические механизмы. Мы не можем разрушить эти уже патогенные грибки, но можем изменить кислотно-щелочное состояния и привести его в норму или сделать более щелочным. Вот именно в этом и состоит наша задача. К сожалению, мы столько времени уделяем болезням, что реально не думаем о том, чтобы сосредоточиться на главной задаче. И поэтому сейчас я постараюсь показать вам эти два состояния (intermediate и term) с помощью слайдов.
|
|
|
| ||
| Слайд №1 | Слайд №2 | Слайд №3 |
Слайд № 1. Это идеальное щелочное состояние крови. Главная задача эритроцитов - принести кислород ко всем другим клеткам. Чем моложе эритроцит, тем больше гемоглобина и больше возможностей впитывать в себя кислород. В основном работают именно молодые эритроциты, они отдают очень большое количество кислорода клеткам. Следствием нормального обеспечения кислородом всех клеток является нормальное состояние иммунной системы, нормальное состояние всех других функций организма. И очень важно, что между понятиями насыщение тканей кислородом и щелочное состояние крови можно поставить знак равенства. И это означает - «хорошее здоровье». И именно в таком состоянии должна быть кровь у человека, каждое утро, когда мы просыпаемся. Но, к сожалению, кровь меняется в течение нашей жизни. Во время жизнедеятельности организм постоянно вырабатывает разные виды кислот: молочная, виноградная, лимонная кислоты. И самое страшное, что меняет рН в кислую сторону (больше, чем все виды деятельности человека) - это стресс или напряжение. Стресс – это именно та составляющая, о которой мы очень часто забываем, когда беседуем с нашим пациентом. Но эта составляющая очень важна для нас, чтобы мы всегда о ней думали и помнили, когда смотрим на экран или в микроскоп.
Каждый день мы добавляем те или иные кислоты в плазму, которая окружает форменные элементы. В обычном состоянии мембрана эритроцита заряжена отрицательно. Когда кислотность в плазме увеличивается, изменяется полярность эритроцитов. Изменение происходит следующим образом: часть мембраны остается отрицательно заряженной, а часть мембраны становится заряженной положительно. Это изменение называется Z-фактор. Когда мы смотрим на картинку, которую нам показывает темнопольный микроскоп, то чем темнее внутренняя часть эритроцита, тем он моложе (1). Те эритроциты, у которых появляется светлое пятно внутри и оболочек, как колечко – это уже зрелые эритроциты (2).
Слайд № 2. Иногда мы даже не можем видеть четко центр (1). Меняется форма эритроцитов. Некоторые, могут быть круглые, а некоторые – овальные (2). Эритроциты, продолговатой или овальной формы, даже чрезмерно щелочные. Ничего страшного, никакого вреда от этого нет.
Иногда, когда вы смотрите на кровь и, в принципе, видите очень хорошую картину, почти идеальную, можно решить, что нет никаких проблем. В этом случае вам нужно посмотреть глубже. Очень важно при этом обратить внимание на лейкоциты. Вы помните, что нормальный лейкоцит (3), в нормальном рабочем состоянии, должен быть в два - три раза больше, чем эритроцит. Очень часто мы можем видеть какие-то гранулы внутри лейкоцита, которые постоянно двигаются. Когда происходит сдвиг в кислую сторону, то кислота проникает внутрь лейкоцитов и, эти гранулы перестают двигаться.